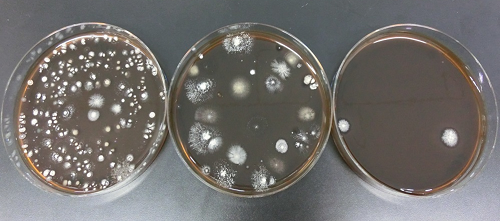
HV培地上に出現した放線菌のコロニー

NBRCニュース 第40号
◆◇◆ ━━━━━━━━━━━━━━━━━━━━━━━━━━━━━━━━ ◆◇◆
NBRCニュース No. 40(2016.8.1)
◆◇◆ ━━━━━━━━━━━━━━━━━━━━━━━━━━━━━━━━ ◆◇◆
NBRCニュース第40号をお届けします。今号は微生物の培養法、微生物あれこれの2つの
連載をお届けします。最後までお読みいただければ幸いです。
================================================================================
内容
================================================================================
1.新たにご利用可能となった微生物株
2.お盆期間中のNBRC微生物株・DNAリソースの発送休止について
3.微生物の培養法(20)放線菌の選択分離法
4.微生物あれこれ(36)微生物の安全な利用に向けた情報の提供について
5.NITE講座「生物遺伝資源の利用に関する国際ルールと規制の基礎」受講生募集
6.NITEバイオテクノロジーセンター展示のお知らせ
================================================================================
1.新たにご利用可能となった微生物株
================================================================================
◆ NBRC株
酵母 45株、糸状菌 16株、細菌 22株が新たにご利用可能となりました。
細菌では、インドネシアの発酵食品に由来する乳酸菌の分譲を開始しました。これらの
中には、乳酸菌ファージの溶原菌(NBRC 112047、112048)や増殖用宿主(NBRC 112043)
が含まれます。また、水田由来のGammaproteobacteriaに属する、タイプIのメタン酸化細
菌Methylomagnum ishizawai NBRC 109438を公開しました。
【詳細】 https://www.nite.go.jp/nbrc/cultures/nbrc/new_strain/new_dna.html
◆ RD株
スクリーニング株(RD株)として、国内の土壌や堆肥などから分離された糸状菌(接合
菌)59株および原油で汚染された土壌などから分離した放線菌・細菌13株を追加いたしま
した。是非、リストをご覧ください。
【詳細】 https://www.nite.go.jp/nbrc/cultures/rd/new_rd.html
【RD株リスト】 https://www.nite.go.jp/nbrc/cultures/rd/available_rd_list.html
================================================================================
2.お盆期間中のNBRC微生物株・DNAリソースの発送休止について
================================================================================
NBRCでは下記のお盆期間中、送付後の微生物の品質を確保するため、微生物株・DNAリ
ソースの発送を一時休止させていただきます。
発送休止期間:平成28年8月8日(月)~8月15日(月)
発送予定:
8月3日(水)午前まで受付分 → 8月4日(木) 発送
8月3日(水)午後~12日(金) 午前まで受付分 → 8月16日(火)以降順次発送
休止期間中にいただきました分譲依頼につきましては、翌営業日以降に順次対応とさせ
ていただきます。また、上記期間中にお急ぎでご利用になりたい場合はご相談ください。
【詳細】 https://www.nite.go.jp/nbrc/cultures/index.html
================================================================================
3.微生物の培養法(20)
放線菌の選択分離法 (浜田盛之)
================================================================================
北里大学の大村 智 特別栄誉教授は、伊豆のゴルフ場近くの土から分離した放線菌か
ら、寄生虫を原因とする病気に極めて優れた効果を示す物質を発見されたことで、昨年
ノーベル生理学・医学賞を受賞されました。その報道の中で、大村先生は昔から「いつで
も土を採集できるようにスプーンと袋を持ち歩いている」というエピソードが紹介されて
いたのをご記憶の方も多いと思います。土を集める作業は容易に想像できると思います
が、ではその集めた土からどのように微生物を取り出すのでしょうか?今回は、薬を作る
微生物「放線菌」を土から分離する方法について、その一例を紹介します。
◆微生物分離の基本的な考え方
微生物を分離するプロセスは大きく三つに分けられます。一つ目は、土などの試料を採
集します。二つ目は、その試料を分離用の培地に接種し、培養します。そして三つ目は、
分離培地上に現れたコロニーを単離・純化します。このプロセスの中で、対象とする微生
物を効率的に分離するために工夫すべきポイントは主に三つあります。一つ目は単純に、
取りたい微生物がなるべく多く生息していそうな試料を集めることです。二つ目は、集め
た試料を培地に接種する前に何らかの処理をして、分離したい微生物以外をできるだけ減
らすことです。三つ目は餌となる培地と培養条件を、分離したい微生物に適したものにな
るように工夫することです。
魚釣りで例えると、この三つは「釣り場(採集する場所や試料の種類)」、「仕掛け
(試料の処理方法など)」、「餌(培地の種類)」と言えます。微生物の分離を行う研究
者は、この三つのポイントについて様々な工夫を凝らし、それらを組み合わせることで、
目的の微生物の分離を試みています。
◆代表的な放線菌の選択分離法
放線菌の代表的な生息場所、つまり「釣り場」として適した試料は土です。森林や畑な
どの肥沃な土壌にはたくさんの放線菌が生息しています。土の種類にもよりますが、土1
グラム中には10^6~10^8個の放線菌が存在するといわれています。しかし、土にはカビや
その他の細菌など他にもたくさんの微生物が生息しており、土という環境の中で少数派の
放線菌を狙って取り出すためには、「仕掛け」と「餌」にも工夫を凝らさなければなりま
せん。そのためには、放線菌という生物の特徴を理解することが重要です。
放線菌は原核生物でありながら、カビのように菌糸を伸張させ、胞子を作るという特徴
があります。胞子は過酷な環境でも生き延びられるよう、熱にも乾燥にも強いという特性
を持っています。そこで、土を集めたらまず紙の上に広げて、室内で一週間程度乾燥させ
ます。水分を失ってカラカラに乾燥した土の中では、胞子を作らない一般的な微生物はそ
の大部分が死滅してしまいます。さらに100℃前後のオーブンで一時間程度加熱すること
で、放線菌以外の微生物をさらに減らすことができます。こうして処理した土は、分離用
の培地に直接パラパラと撒くか、滅菌水に懸濁して段階的に希釈してから、その液を培地
に撒くかのいずれかの方法で接種します。これらは一見すると単純な「仕掛け」ですが、
この前処理をするだけでも放線菌の分離頻度を大幅に高めることができます。
また、「餌」となる培地についても紹介します。放線菌は生育が遅く、生育日数が一般
的な細菌やカビと比べると3~10倍は必要になるため、栄養豊富な培地では放線菌以外の
生育が早くて強い微生物が旺盛に増えてしまいます。そこでなるべく放線菌だけが利用で
きるような餌を考える必要があります。放線菌の代表的な分離培地として、腐植酸-ビタ
ミン寒天培地(HV培地)があります(1)。腐植酸は落ち葉などが土の中の微生物によって
分解され、最後に残る物質です。ほとんどの微生物はこの腐植酸を餌として利用すること
ができませんが、放線菌は腐植酸を餌として利用することができます。この培地中に、カ
ビや放線菌以外の細菌の増殖を抑える働きのある抗生物質を添加したものが有効な放線菌
の分離培地となります。この培地を「餌」として、前述の「仕掛け」と組み合わせること
で、極めて高い確率で放線菌を分離することが可能となります。
人類を救うかもしれない放線菌は、案外身近な土に眠っているのかもしれません。みな
さまも放線菌の分離に挑戦してみてはいかがでしょうか?

集めた土を紙の上で乾燥させている様子

HV培地上に出現した放線菌のコロニー
(左から1,000倍、10,000倍、100,000倍希釈して接種したもの)
【引用文献】
(1)Hayakawa, M. & Nonomura, H. (1987). Humic acid-vitamin agar, a new medium
for the selective isolation of soil actinomycetes. J. Ferment. Technol.,
65, 501-509.
【参考文献】
早川正幸 (1990). 土壌放線菌の選択分離方法および分布に関する研究.
Actinomycetol., 4, 103-112.
================================================================================
4.微生物あれこれ(36)
微生物の安全な利用に向けた情報の提供について (黄地祥子)
================================================================================
微生物を安全に取り扱うには、利用する微生物の危険度を予め把握しておく必要があり
ます。微生物の危険度を判断する一つの指標として、世界保健機関(WHO)等が定めてい
るバイオセーフティレベル(BSL)があります。WHOでは、それぞれの微生物の潜在的な危
険度(病原性、予防法や治療法の有無、感染経路、疫学的状況)を勘案し、微生物を実験
室で安全に取り扱うためのBSLを4段階(BSL1~BSL4)に分類しています(1)(2)。国内で
は、国立感染症研究所および日本細菌学会が病原体のBSL分類のリスト(日本細菌学会で
は細菌のみ)を公開しています。
また、利用に当たって法規制の適用を受ける微生物種やDNA等の生物資源もあります。
病原体の管理(所持や輸出入等)に関する法律としては「感染症の予防及び感染症の患者
に対する医療に関する法律(感染症法)」、「家畜伝染病予防法(家伝法)」、「植物防
疫法」、「外国為替及び外国貿易法(外為法)」、「遺伝子組換え生物等の使用等の規制
による生物の多様性の確保に関する法律(カルタヘナ法)」などがあります。
このように病原体のBSLや法規制に関わる情報は、しばしば複数の法令文書等にまた
がって掲載されています。さらに、家伝法の監視伝染病に関する規制では主に疾病名で指
定されており、規制対象となっている病原体の学名を調べる際には、別資料を参照する必
要があります。また、分類体系の変更により、作成・更新時期の違いでBSLリストや法令
において同じ病原体が異なる学名(旧名、異名)で掲載されていることもありますので、
特に作成時期が古い資料を参照する場合には注意しなければなりません。
それぞれの法律の目的にしたがって、法律上での病原体の定義や取扱いレベルが異なる
点にも注意が必要です。例えば、チフス菌として知られるSalmonella enterica subsp.
enterica serovar Typhiは感染症法で四種病原体等として指定されていますが家伝法では
規制対象外です(3)。一方、家伝法においては監視伝染病の病原体となっているサルモネ
ラ症の原因菌サルモネラ・ティフィムリウムは(4)、現在はSalmonella enterica subsp.
entericaに分類され、この亜種の一つの血清型(Salmonella enterica subsp. enterica
serovar Typhimurium)です。この菌は感染症法では規制対象外であり、同じサルモネラ
菌であっても、血清型の違いだけで法律上での病原体の取扱いレベルが異なります。
そこで、NBRCでは微生物の安全で適切な利用のために、ヒトや動物に病気を起こす微生
物(細菌)のBSLや法規制等の情報をまとめた「微生物有害情報リスト(以下、リスト)」
を整備し公開しています。現在リストから提供しているのは、日本細菌学会、国立感染症
研究所、ドイツの微生物細胞培養コレクション(DSMZ)が公開している細菌のBSL分類の
情報、感染症法、家畜伝染病予防法、カルタヘナ法、および外為法の関連法令で規制等の
対象として定められている病原細菌についての情報となります。このリストでは、散在す
る病原細菌に関する既知情報を一元化し、学名(旧名、異名を含む)から一度に全情報を
見ることが可能となっていますので、本リストを使用することで、微生物の有害性に関わ
る情報調査の時間が短縮できます。
このリストは、学名の追加や変更などは定期的に、また関連法律の改正時には随時更新
しています。エクセル形式でダウンロードすることも可能ですので、ぜひ皆様の業務に本
リストをご活用ください!
【微生物有害情報リスト】 http://www.nite.go.jp/nbrc/list/risk/
【参考文献】
(1)World Health Organization Laboratory Biosafety Manual Third Edition
http://www.who.int/csr/resources/publications/biosafety/Biosafety3_j.pdf
(2)バイオメディカルサイエンス研究会(編) バイオセーフティの事典―病原微生物
とハザード対策の実際 みみずく舎
(3)岡田淳(編) 必携バイオセーフティ指針 医歯薬出版
(4)家畜伝染病予防法施行規則
http://elaws.e-gov.go.jp/search/elawsSearch/elaws_search/lsg0500/detail?lawId=326M50010000035
================================================================================
5.NITE講座「生物遺伝資源の利用に関する国際ルールと規制の基礎」受講生募集
================================================================================
生物多様性条約や名古屋議定書、カルタヘナ議定書など生物遺伝資源を利用するための
国際ルールや安全性確保に関する規制について解説します。また、最近の技術動向を踏ま
えた国際的な規制の方向性、実際に生物遺伝資源を利用するために必要な知識について講
座を開講します。参加費は無料です。皆様のご参加をお待ちしております。
日時:平成28年9月8日(木)14:30~17:30
場所:独立行政法人製品評価技術基盤機構
東京都渋谷区西原2-49-10
http://www.nite.go.jp/nite/aboutus/jigyosho/nite_map.html
京王新線幡ヶ谷駅から徒歩約10分
小田急線・東京メトロ千代田線代々木上原駅から徒歩約15分
講義名:(1) 生物遺伝資源の利用に関する国際ルールと規制
(2) 新たな技術開発の動向と国際的な規制の動向
(3) 生物多様性の保全と適正な利用のために
(4) 遺伝子組換え生物の安全な利用のために
詳細な内容やお申込み方法につきましては、以下のウェブページをご覧ください。
【詳細】 http://www.nite.go.jp/nbrc/information/2016_bio-kouza.html
================================================================================
6.NITEバイオテクノロジーセンター展示のお知らせ
================================================================================
以下に出展いたします。ブースではお立ち寄りいただいた皆様からのご相談やご質問に
もお答えします。是非お越しください。
第31回 日本放線菌学会大会
日時:平成28年9月8日(木)~9月9日(金)
場所:東京大学弥生講堂 一条ホール/アネックス
http://webpark1257.sakura.ne.jp/actinomycetes/index.html
第68回 日本生物工学会大会
日時:平成28年9月28日(水)~9月30日(金)
場所:富山国際会議場 3F
http://www.sbj.or.jp/2016/
MALDI-TOF MS(細菌の高精度迅速同定と糸状菌の前処理法についての詳細はポスター発
表で)、ゲノム解析・アノテーション技術、公開データベース等の紹介をします。
================================================================================
編集後記
================================================================================
「機能性表示食品」制度がスタートしてから1年以上が経ちました。株式会社富士経済
の報告では、2016年度の機能性表示食品の市場規模は699億円(2015年度見込み比2.3倍)
にまで拡大するとの予測です。消費者庁のウェブサイトで確認したところ、現時点(2016
年7月)での届け出件数は300品目以上、このうち約一割がビフィズス菌を機能性関与成分
とした商品でした。近年、腸内フローラと健康の関連性が次々と明らかになってきている
状況を踏まえると、今後、ますます腸内細菌を活用した健康食品の開発に注目が集まりそ
うです。(AY)
◆◇◆ ━━━━━━━━━━━━━━━━━━━━━━━━━━━━━━━━ ◆◇◆
・画像付きのバックナンバーを以下のサイトに掲載しております。受信アドレス変更、
受信停止も以下のサイトからお手続きいただけます。
https://www.nite.go.jp/nbrc/cultures/others/nbrcnews/nbrcnews.html
・NBRCニュースは配信登録いただいたメールアドレスにお送りしております。
万が一間違えて配信されておりましたら、お手数ですが、下記のアドレスにご連絡く
ださい。
・ご質問、転載のご要望など、NBRCニュースについてのお問い合わせは、下記のアドレ
スにご連絡ください。
・掲載内容は予告なく変更することがございます。掲載内容を許可なく複製・転載され
ることを禁止します。
・偶数月の1日(休日の場合はその前後)に配信します。第40号は2016年10月3日に配
信予定です。
編集・発行
独立行政法人製品評価技術基盤機構(NITE)バイオテクノロジーセンター
NBRCニュース編集局(nbrcnews@nite.go.jp)
◆◇◆ ━━━━━━━━━━━━━━━━━━━━━━━━━━━━━━━━ ◆◇◆
お問い合わせ
-
独立行政法人製品評価技術基盤機構 バイオテクノロジーセンター
生物資源利用促進課
(お問い合わせはできる限りお問い合わせフォームにてお願いします)
-
TEL:0438-20-5763
住所:〒292-0818 千葉県木更津市かずさ鎌足2-5-8 地図
お問い合わせフォームへ